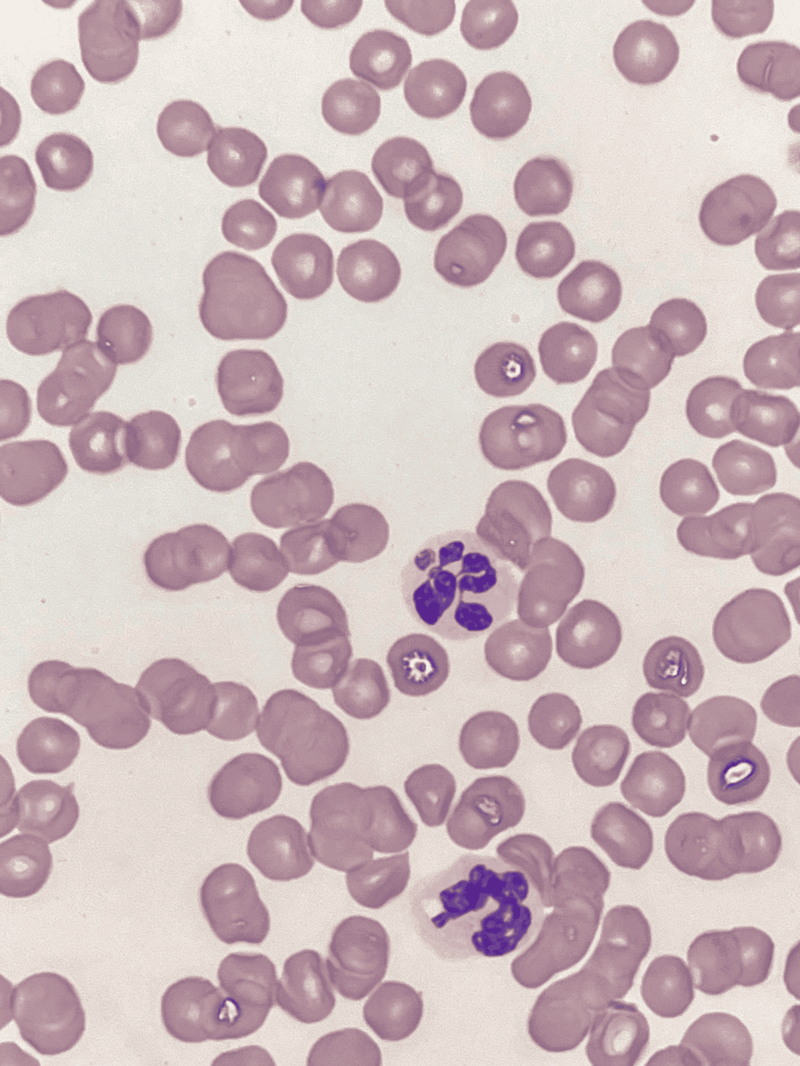
Microscopic image of cancer cells with purple stained nuclei, highlighting cellular abnormalities.

Flea and Tick Prevention and Treatment for Dogs: Effective Solutions for Pet Owners
Keeping dogs healthy involves taking proactive steps to avoid potential problems before they start. One important aspect of this is the use of flea and tick preventatives. These monthly treatments play a crucial role in protecting pets from the discomfort and health issues that these pests can cause.

Fleas and ticks can bring a variety of problems for dogs, including skin irritations and more serious diseases. By giving regular preventive treatments, dog owners can ensure their pets enjoy a healthier and happier life.
Understanding Fleas and Ticks
Life Cycle of Fleas and Ticks
Fleas go through four stages in their lifecycle: egg, larva, pupa, and adult. The whole process can take as little as three weeks. Flea eggs are laid on the host and can fall off into the environment. Larvae hatch from these eggs and feed on organic material. The pupal stage is a cocoon-like phase where they develop into adults. Adult fleas then hop onto a host, where they feed and reproduce.

Ticks have a different lifecycle, consisting of four stages: egg, larva, nymph, and adult. After hatching from eggs, larval ticks, often called seed ticks, seek out hosts for blood meals. They then moult into nymphs and need another host. After one more moult, they become adults which require another blood meal before reproducing. Ticks can take up to two years to complete their life cycle, depending on the environment.
Risks and Diseases Associated With Parasites
Fleas can cause problems like itching, allergic reactions, and skin infections. They are also carriers of tapeworms, which dogs can ingest while grooming. In severe cases, a flea infestation can lead to anaemia in dogs.

Ticks are known carriers of diseases such as Lyme disease, Rocky Mountain spotted fever, and Ehrlichiosis. These illnesses can cause symptoms like fever, fatigue, and swollen joints in dogs. Early detection is important for effective treatment. To protect dogs, regular checks and a suitable prevention plan are essential.
Why Is Preventing Fleas and Ticks Essential for Dogs?
Fleas and ticks are parasites that live on the skin of dogs, drawing blood from them. Flea bites can lead to problems like allergies, dermatitis, anaemia, itching, and infections. Tick bites might cause infections, abscesses, paralysis, or even death.
Lyme Disease

Dogs can get infected by lyme disease when bitten by an infected tick. This is caused by Borrelia burgdorferi, and is most commonly transmitted by the black legged tick. Dogs infected with this disease usually experience high fevers and may appear to have recurring limp with swollen joints.
Anaplasmosis
This is caused by Anaplasma platys, transmitted by the brown dog tick, and Anaplasma phagocytophilum, carried by the black legged tick. Infected dogs appear to be lethargic with fever, joint pain, and anorexia. Clinical signs are similar with lyme disease, and co-infection can also occur.
Tests can be made by the veterinarian to determine which disease your dog might be infected with. Proper identification should be done to determine the correct course of treatment.

Bartonellosis
Bartonellosis is caused by fleas, ticks, lice and sand flies. Symptoms include fever, sore muscles, and nose bleeds. This disease is zoonotic, and can be passed to humans though scratch or bites, hence, the need for immediate treatment once symptoms are observed in the dog.
Rocky Mountain Spotted Fever
This disease is caused by Rickettsia rickettsii, and is usually transmitted by the American dog tick, Rocky Mountain wood tick and brown dog tick. Symptoms of infection include fever, lethargy, swollen joints, abdominal pain, and difficulty in breathing.

This disease can possibly be fatal when left untreated or when medication is given too late through the course of the disease.
Tapeworms

Tape worm is a type of intestinal parasite that is transmitted to dogs through ingestion of an infected flea. Owners can observe scooting, or dogs dragging their bottoms through the floor, in dogs infected with tapeworm. Tapeworms do not usually cause serious health concerns, unless the worm load in the dog is severe, which can cause anaemia.
Babesiosis
Dogs contract babesiosis through the bite of an infected tick. Babesia then infects the red blood cells of the dog, causing severe clinical signs such as systemic shock. Other clinical signs that owners should watch out for include pale gums, dark urine, and fever.

Keeping dogs free from fleas and ticks is important because some diseases can also affect humans. Ensuring that these pests stay away protects both dogs and people from illness and discomfort. This safeguarding is vital to maintain a healthy environment both for pets and their families.
Prevalence and Seasonality
Fleas and ticks affect dogs differently based on location and time of year. Knowing where these parasites thrive and when they are most active helps in taking preventive measures effectively.
Geographical Distribution
Fleas and ticks are found all over the world, but their numbers and types can vary. In warm, humid climates, fleas can be a year-round problem.

Ticks prefer wooded, grassy areas and tend to be more common in the eastern United States. The Pacific coast also sees a high tick population. Dogs in rural places might encounter them more often than city dogs. Different ticks carry different diseases, so knowing the type in your area is important.
Areas with colder winters can see a drop in flea and tick activity during the frostier months. Yet, they can still be a problem indoors or during mild winters. Travel with dogs can expose them to new parasite risks in different regions. Local vets usually offer the best advice tailored to geographical needs.
Seasonal Activity Patterns
Flea and tick activity often peaks in spring and summer, declining as it gets colder. In many areas, fleas become active around early spring and remain until fall.

Ticks often follow a similar pattern, emerging as temperatures rise. Spring and early summer are especially critical times to be vigilant. During these seasons, dog owners should check their pets more frequently for ticks and fleas. Use preventive measures like topical treatments or collars more consistently.
In warmer areas, or with warmer winters, fleas and ticks might not become inactive at all. Regular treatment is necessary year-round in these climates to keep dogs safe from these persistent pests.
When Should Dogs Get Flea and Tick Protection?
Fleas and ticks can live in many areas and carry diseases. They can harm both dogs and humans. Dogs should begin flea and tick protection at 8 weeks old. Prevention should continue all year, every year, for the rest of the dog’s life. This helps keep them safe and healthy from these pests.
Selecting a Combo Flea and Tick Medicine for Dogs
Method of Use

Flea and tick medicines come in two main types, chewable tablets and topical medications that are usually applied to your dog’s skin from the shoulders down the back. Topical treatments are great for picky eaters but keep them away from kids and other pets until dry.
These should not be used for dogs that love water activities because it might wash away the product. Chewable tablets offer convenience, but owners should ensure their dog eats and doesn’t spit out the pill.
Location Matters

The region where you live can influence the type of pests that threaten your pet. Some areas may have a higher population of certain parasites. Checking resources like the Companion Animal Parasite Council helps determine which pests are common in your area.
| Region | Common Parasites |
| Northern States | Fleas, ticks, heartworms |
| Southern States | Ticks, mosquitoes, intestinal worms |
Outdoor Exposure

Dogs that frequent parks, forests, or play in backyards may face more fleas and ticks. Even dogs that mostly stay indoors can be exposed to parasites hitching a ride on other animals or people. So, regular protection is advisable.
| Risk level | Place |
| High risk | Wooded areas, dog parks |
| Moderate risk | Backyards, local parks |
| Low risk | Urban settings, mostly indoor environments |
MDR-1 Genetic Factor

Breeds like Collies or Australian Shepherds sometimes have a genetic trait known as MDR-1. This can make processing certain drugs difficult. Getting your dog tested for this gene is wise, and consulting with a vet ensures the safest product choice.
Activity and Lifestyle

Certain activities increase parasite exposure. Working dogs or those spending time outdoors are at higher risk. Breeds known for activity, like hunting or herding, need more comprehensive protection.
Very active dogs such as field workers may need to be monitored more for fleas and ticks, while moderately active dogs who love going on regular walks in the park and frequent dog park visitors may also be exposed to parasites. Indoor dogs have the lowest chance of parasite exposure.
Age and Growth Stage

Young puppies or smaller breeds need products carefully chosen for their age and weight. Many preventives are only suitable for dogs older than 6 to 8 weeks. Checking product labels or consulting a vet helps in selecting a suitable option.
Age Guidelines for Common Treatments:
| Life Stage | Appropriate Product Types |
| Puppies (6-8 wks) | Mild topical liquids, age-approved chewables |
| Adult Dogs | Standard oral or topical formulations |
Health Issues
Dogs with certain health concerns like seizures or allergies need cautious decision-making. Medicines with isoxazolines should be used with care due to possible seizure risks. Consultation with a vet is advised whenever a dog has had previous allergic responses or other health issues.

Taking these factors into account helps to ensure your dog’s pest prevention is both effective and safe. Seek regular advice from your veterinarian to tailor the best strategy for your pet’s needs.
Non-Prescription vs. Doctor-Approved Flea and Tick Remedies
Non-Prescription Flea and Tick Products

Non-prescription flea and tick treatments can be purchased without needing to see a vet. These products are widely available online and in pet stores. Consult with a vet to ensure any non-prescription treatment is safe for your pet.
Doctor-Approved Flea and Tick Products

Treatments requiring a vet’s prescription usually cost a bit more than over-the-counter products. Many vets prefer these as they are often more reliable and safer for pets.
Preventative Treatments
There are several options for keeping dogs safe from fleas and ticks. These include topical solutions, oral medications, collars and sprays, and some natural alternatives. Each method can be effective, but it is important to consider the specific needs of the dog before choosing a treatment.
Topical Solutions
Topical solutions are applied directly to a dog’s skin, often between the shoulder blades. These treatments are popular for their simplicity in application and effectiveness. Some contain chemicals that kill fleas and ticks on contact, while others act as repellents.

Most topical solutions show results within a few hours. They typically provide protection for up to a month. Owners should always follow instructions carefully and avoid bathing dogs shortly after application, as this can reduce effectiveness.
Oral Medications
Oral medications are another efficient way to protect dogs. These products are usually given as a chewable tablet or pill once a month. They work by affecting fleas or ticks when they bite the dog, causing them to die quickly.

One advantage is rapid effectiveness—sometimes within hours. Also, oral medications are less likely to lose potency due to swimming or bathing. Owners need to ensure dogs eat the right dose for their weight to get the best protection.
Collars and Sprays
Flea and tick collars release chemicals that spread over the dog’s body, offering protection for several months. They can be a convenient option as they require less frequent attention. However, it’s important to fit them properly so dogs remain comfortable.

Sprays act quickly and can be used for both immediate relief and longer-term prevention. They can be applied directly to the pet or used on bedding and living areas. It’s crucial to use dog-specific sprays, as some products meant for other animals can be harmful.
Natural and Homemade Alternatives
For those looking to avoid chemical treatments, natural options are available. Essential oils like lavender or peppermint are sometimes used, though care should be taken to ensure they’re safe for dogs.

Homemade sprays using diluted vinegar or lemon mixtures can be applied to a dog’s coat for some protection. While not as potent as commercial products, these alternatives may suit those concerned about chemicals. Owners must research thoroughly and consult a vet when considering these options.
Administering Medication
Giving the right medication to a dog involves care and attention. It is important to understand the proper dosage for the pet and how to read medication labels correctly.
Dosage and Safety Considerations
Determining the right dosage is crucial for a dog’s health. The dosage depends on the dog’s weight, age, and current health condition. Always follow the vet’s guidelines. Overdosing can lead to health problems, while underdosing might not effectively eliminate fleas and ticks.

Make sure the medication is suitable for the dog’s size. Never use dog medications on other pets like cats, as they might have different ingredients that could harm them. Be cautious about allergic reactions or side effects. Watch for signs like vomiting or lethargy, and contact a vet if these occur.
Reading and Understanding Labels
Reading medication labels ensures correct administration. Labels provide important information like active ingredients, usage instructions, and expiration dates. Check if the medication is topical or oral.

Pay attention to any warnings or contraindications, especially for dogs with existing health problems. Labels might also suggest storing conditions. It’s important to keep medications out of reach of children and other pets.
Follow each step listed on the label meticulously. If unsure, consult a vet to clarify any doubts and ensure safe use of the medication.
Treatment Options
Dogs can encounter fleas and ticks unexpectedly, so knowing how to act quickly is vital. Immediate steps should be taken after an infestation, and consulting a veterinarian is essential to ensure the best health outcomes for your pet.
Immediate Actions After Infestation
When discovering a flea or tick infestation, the first step is to isolate the pet to prevent spreading. Use a flea comb to remove visible fleas and ticks from the dog’s fur. Bathing the dog with a medicated shampoo can help eliminate insects.

Clean the pet’s environment thoroughly. This includes washing bedding and vacuuming carpets and furniture. It’s crucial to break the flea life cycle by addressing the environment, not just the pet itself, to prevent re-infestation.
Consulting with a Veterinarian
After initial treatment, a visit to the veterinarian ensures the pet receives comprehensive care. A vet can recommend effective topical or oral medications to eliminate fleas and ticks.

They may suggest monthly prevention products to protect against future infestations. Veterinarians can also check for any diseases or allergies caused by flea and tick bites. Regular vet visits are key steps in a proactive health routine, ensuring a pet’s ongoing well-being.
Dog-Friendly Habits for Prevention
Keeping dogs free from fleas and ticks involves maintaining their health and surroundings. Regular grooming and health checks ensure early detection of pests, while keeping living areas clean prevents infestations.
Regular Grooming and Health Checks
Grooming plays a key role in keeping dogs flea and tick-free. Brushing dogs regularly helps remove loose fur and check for parasites. Use a fine-toothed comb to look for fleas and ticks, especially in warm spots like the belly and ears.

Regular vet check-ups catch any infestations early. Discuss flea and tick prevention with the vet. They might suggest preventive treatments like monthly topical solutions or oral medications. Consistent monitoring and professional advice help protect the dog from future issues and keep them comfortable.
Sanitising Indoor and Outdoor Environments
Clean environments minimise the chance of infestation. Indoors, vacuum carpets and furniture often to remove fleas or eggs. Wash pet bedding in hot water weekly. Use flea treatments designed for carpets if necessary.

Outdoors, keep the yard tidy by mowing the grass and trimming bushes. Fleas and ticks thrive in tall grass and leafy areas. Consider using pest-control treatments around entry points. Ensure the dog’s environment supports their health and reduces exposure to pests, keeping them safe and happy.